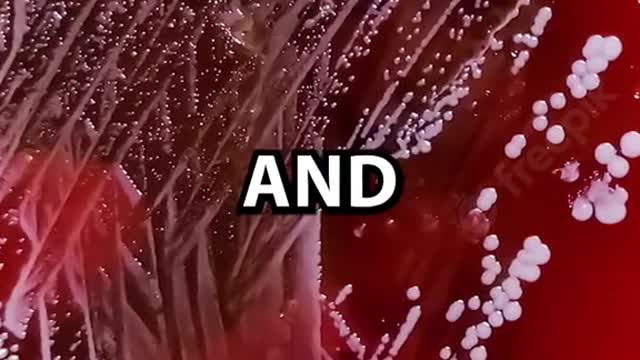
You Have To See This!!!

Premium Only Content
This video is only available to Rumble Premium subscribers. Subscribe to
enjoy exclusive content and ad-free viewing.
You Have To See This!!!
Loading comments...
-
 1:14:05
1:14:05
DeVory Darkins
15 hours agoDemocrats get BAD EPSTEIN NEWS after major mistake
153K131 -
 2:29:10
2:29:10
Badlands Media
9 hours agoDevolution Power Hour Ep. 406: Cracks in the Empire
235K22 -
 2:55:16
2:55:16
TimcastIRL
8 hours agoNEW Epstein Emails Drop, Dems Claim TRUMP KNEW, Congress Forces Epstein Release Vote | Timcast IRL
252K108 -
 1:19:53
1:19:53
Barry Cunningham
7 hours agoBREAKING NEWS: PRESIDENT TRUMP RE-OPENS THE UNITED STATES GOVERNMENT!
42.1K18 -
 20:47
20:47
The White House
7 hours agoPresident Trump Signs Senate Amendment to H.R. 5371
34.2K33 -
 4:37:57
4:37:57
Drew Hernandez
23 hours agoNEW EPSTEIN EMAIL DROP FULLY POLITICIZED
59.4K19 -
 1:44:01
1:44:01
Tucker Carlson
6 hours agoTucker Carlson on the Israel First Meltdown and the Future of the America First Movement
65.9K419 -
 4:02:08
4:02:08
Alex Zedra
6 hours agoLIVE! Phasmaphobia New Map!
55.4K2 -
 2:16:06
2:16:06
Laura Loomer
8 hours agoEP155: Jihad Makes Its Move On The White House
47.3K62 -
 2:18:47
2:18:47
TheSaltyCracker
8 hours agoDem's Epstein Drop Backfires ReeEEStream 11-12-25
109K217